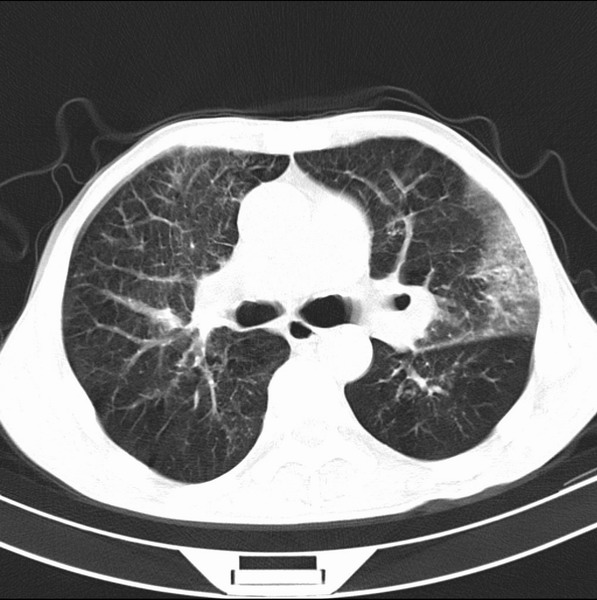

医影在线
标题: CT19600:能否诊断为转移? [打印本页]
作者: frzh 时间: 2009-4-26 20:10
标题: CT19600:能否诊断为转移?
女、55
3年前盲肠癌、一年半前诊断膀胱癌,现在呼吸困难,临床考虑为肺转移
请问胸部ct如何诊断?能否排除淋巴管炎,纵隔窗没有问题。

[本贴已被 frzh 于 2009-4-26 12:12:05 修改过]
[本贴已被 aosangwa 于 2009-4-26 14:46:53 修改过]
[本贴已被 jiajie 于 2009-4-26 20:33:45 修改过]
作者: frzh 时间: 2009-4-26 20:21
未发现确切,暂时考虑炎症,建议抗炎治疗后复查
作者: panyishengct 时间: 2009-4-26 20:48
考虑间质性病变,癌性淋巴管炎可能.
作者: haha215315 时间: 2009-4-26 20:53
转移,癌性淋巴管炎。
作者: 随光逐影 时间: 2009-4-26 21:06
标题: 回复:能否诊断为转移?
以下是引用panyishengct在2009-4-26 12:48:00的发言:[br]考虑间质性病变,癌性淋巴管炎可能.
作者: aosangwa 时间: 2009-4-26 22:36
标题: 回复:能否诊断为转移?
以下是引用panyishengct在2009-4-26 12:48:00的发言:[br]考虑间质性病变,癌性淋巴管炎可能.
作者: tao772 时间: 2009-4-26 22:40
建议抗炎后复查,不除外癌性淋巴管炎。
作者: 深泽交通 时间: 2009-4-26 22:47
炎性并间质纤维化
作者: zjzjr 时间: 2009-4-26 23:02
炎性并间质纤维化,请询问病史,如用过平阳霉素或其他化疗药.可能为药物引起的间质纤维化.
作者: abecedarian 时间: 2009-4-26 23:47
炎性并间质纤维化,请询问病史,如用过平阳霉素或其他化疗药.可能为药物引起的间质纤维化.
作者: 卜一 时间: 2009-4-26 23:48
考虑间质性病变,癌性淋巴管炎可能.支持!
作者: 黑白光影 时间: 2009-4-27 00:26
支持考虑间质性病变,癌性淋巴管炎可能.
作者: zsl6918 时间: 2009-4-27 00:29
炎性并间质纤维化,请询问病史,如用过平阳霉素或其他化疗药.可能为药物引起的间质纤维化.
欢迎光临 医影在线 (http://bbs.radida.com/bbs/) |
Powered by Discuz! X3.2 |